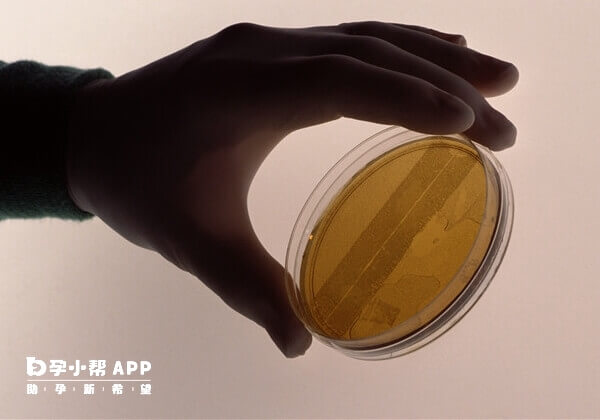
7细胞1级胚胎的成功率有55%左右

7C1胚胎属于优质胚胎,具有较高的移植成功率和发育潜力。根据临床数据,7C1胚胎移植成功率可达50%-60%左右,具体移植着床率,还要因因个体差异和子宫内膜条件而异。如果女性身体条件良好(如子宫内膜厚度适宜、内分泌正常),该胚胎有较大机会成功着床。

鲜胚只发育到3天的胚胎,医生通常会根据生长速度、卵裂形态、胚细胞碎片及胚的染色体是否正常等仅评级,一般常用A、B、C、D来表示胚胎等级,胚的质量A→D呈递减趋势,也就是说A级胚质量、发育潜力等均优于其他胚。如8c1、9c1、7c1等,第一个是细胞的数量,第二个是胚胎的整体质量。 7细胞1级胚胎也就是7c1胚胎,其中的“7c”也就是代表着细胞的数目,“1”就是一级胚胎且细胞大小均等,透亮,胞质无颗粒,碎片率0%-5%,综合的看7c1胚胎是优质的。

移植7c1胚胎的成功率还是比较高的,通常能达到55%左右,而一级胚胎往往也是最好的,虽然受精卵的分裂规律一半在生长到第三天的时候应该有8个细胞,但因多种情况,所以具有6-10细胞的胚胎都是可以移植的。
文章更新时间:2025-08-1413:47:07
位姐妹
高龄/绝经试管
助孕攻略群
位姐妹
不孕不育
助孕经验群
位姐妹
染色体异常
备孕交流群
位姐妹
三代/四代试管
助孕交流群